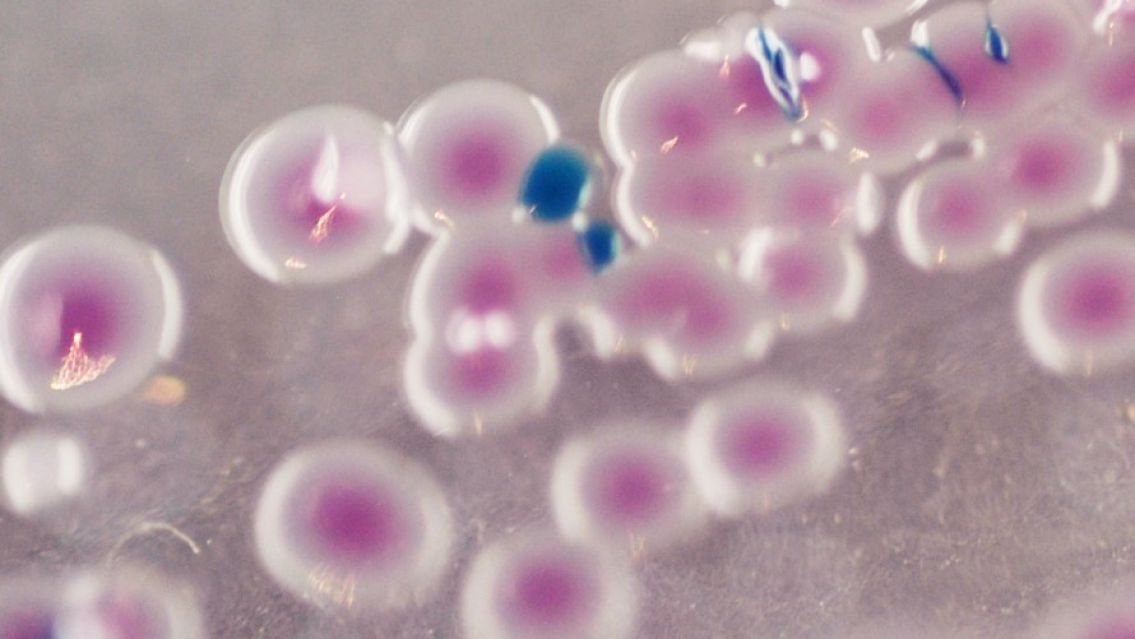
Un peligrosa bacteria causó un brote en Chile: ¿qué es el Vibrio parahaemolyticus?

Un peligrosa bacteria causó un brote en Chile: ¿qué es el Vibrio parahaemolyticus?
Se encendieron las alarmas y la Seremi de Salud hace un llamado urgente a la prevención en Coquimbo.
La Seremi de Salud de Coquimbo emitió una alerta luego de confirmar un brote de Vibrio parahaemolyticus, una bacteria presente en mariscos crudos, que afectó a una familia que consumió este tipo de alimentos sin la debida cadena de frío.
La autoridad sanitaria instó a la población a evitar el consumo de mariscos crudos y a adquirir productos del mar en lugares autorizados que cumplan con las normativas sanitarias, manteniendo la cadena de frío y practicando altos estándares de higiene en su manipulación.
La temporada estival en Chile ha registrado un aumento significativo de brotes alimentarios, con más del 80% relacionado con el consumo de pescados y mariscos. La Autoridad Sanitaria Regional destaca que más del 55% de estos casos están vinculados al consumo de jurel y al consumo de mariscos y pescados crudos, como ceviches y mariscales. Los brotes han ocurrido mayormente en hogares, seguidos por restaurantes y caletas.
Ante esta situación, se emiten una serie de recomendaciones para la adquisición, manipulación y consumo de productos del mar, incluyendo la compra en lugares autorizados, el adecuado almacenamiento refrigerado, la higiene personal y de utensilios, y la cocción adecuada de los alimentos para prevenir la contaminación por Vibrio parahaemolyticus u otros agentes patógenos.
Es importante estar alerta a los síntomas de una intoxicación alimentaria por Vibrio parahaemolyticus, como diarrea, cólicos abdominales, náuseas y vómitos, y buscar atención médica si se presentan.
Además, se detallan los criterios para reconocer pescados y mariscos en buen estado, incluyendo características como agallas rojas, ojos brillantes, carne firme y caparazón cerrado, entre otros.
El llamado a la prevención es fundamental, especialmente en una temporada en la que las altas temperaturas favorecen la proliferación de bacterias como Vibrio parahaemolyticus en productos del mar, y donde el consumo de mariscos y pescados es frecuente.

Comentarios